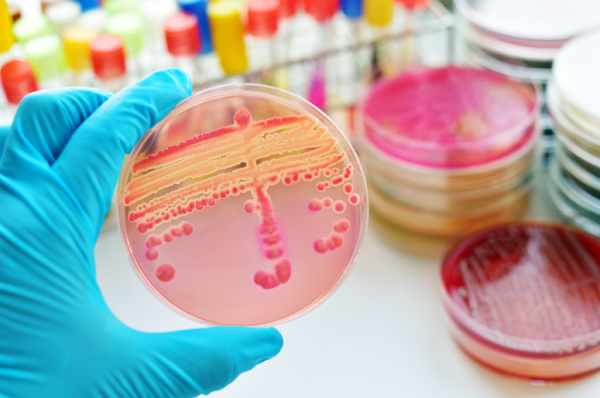
Сепсис

Диагностика септического шока - критерии
Добавил пользователь Дмитрий К. Обновлено: 29.01.2026
Сепсис и септический шок - клиника, диагностика
Многие годы сепсис и септический шок остаются одной из самых актуальных проблем интенсивной терапии. Частота тяжелого сепсиса среди пациентов ОРИТ составляет от 2% до 18%, а септического шока -3-4%. Примечательно, что в ОРИТ сепсис развивается почти в 30 раз чаще, чем в других клинических отделениях больниц.
Увеличению частоты возникновения сепсиса и септического шока способствуют постарение населения, рост продолжительности жизни лиц с тяжелыми хроническими заболеваниями, значительная частота иммунодефицитных состояний у населения, рост штаммов микроорганизмов, резистентных к антибактериальной терапии, связанный с неконтролируемым назначением антибиотиков, применение в интенсивной терапии препаратов, снижающих иммунитет (цитостатаки, гормоны), повышением инвазивности лечения (расширением показании к обширным операциям, длительная катетеризация сосудов, использование экстракорпоральной детоксикации), нарушение правил асептики и антисептики.
Частота грамположительного и грамотрицательного сепсиса встречается практически одинаково - в 39 и 40% случаев соответственно. В 21% случаев диагносцируются полимикробные ассоциации. Это произошло в результате увеличения роли таких бактерий, как Streptococcus spp., Enterococcus spp., Staphylococcus spp., причем среди них отмечается рост метициллинрезистентных штаммов. Выросла частота сепсиса, вызванного рефрактерными к антибактериальной терапии бактериями (Р. Aeruginosa, Acinetobacter spp., Klebsiella spp.), которые, как правило, выступают в качестве возбудителей нозокомиальной инфекции. Увеличение продолжительности жизни больных, перенесших критические состояния, широкое использование комбинаций цефалоспоринов с ами-ногликозидами обусловили появление новых "ужасов" иифектологии -Enterococcus faecium, Stenothrophamonas maltophylia, Flavobacterium spp. и др. У больных, находящихся в стационаре более трех недель и получавших глюкокортикостероиды и парентеральное питание, сеансы гемодиализа, возросла частота грибкового (кандидозного) сепсиса.
Наиболее вероятная этиология сепсиса в зависимости от локализации очага инфекции представлена в таблице.

Несмотря на использование самых современных методов интенсивной терапии, достаточно высокой остается летальность, которая при тяжелом сепсисе и септическом шоке составляет 60-70%.
Высокой летальности способствуют поздняя диагностика, неадекватное хирургическое лечение и антибактериальная терапия, полимикробные инфекции, грибковая суперинфекция.
Сепсис классифицируется по темпу развития, по локализации, по виду возбудителя и стадии компенсации.
Клиника и диагностика сепсиса
В 1992 году была сформулирована концепция сепсиса на основе синдрома системного воспалительного ответа (ССВО), которая вошла в клиническую практику большинства стран мира, включая Россию. Главными достоинствами концепции являются простота диагностических критериев, четкое определение реально встречающихся в клинической практике ситуаций, возможность установления диагноза в короткий срок в лечебном учреждении любого уровня.
Бактериемия является одним из возможных, но необязательных признаков сепсиса. Даже при самом скрупулезном соблюдении техники забора крови и использовании современной технологии, как правило, в среднем высев микроорганизмов не превышает 45%, причем при сепсисе положительные результаты посева достигают 17%, при тяжелом сепсисе - 25%, при септическом шоке - 60-70%.
Клиническое значение результатов высева заключается в подтверждении диагноза и определении этиологии инфекционного процесса, обоснованности схемы и оценке эффективности интенсивной терапии, доказательстве механизма развития сепсиса (например, катетеризация).

Обнаружение микроорганизмов в крови у пациентов без признаков ССВО должно расцениваться как транзиторная бактериемия, часто возникающая после различных диагностических процедур.
Одним из первых проявлений ранней стадии септического шока (гипердинамическая фаза) является гипертермия (до 40-41 °С) с ознобами, сочетающаяся с тахипноэ и тахикардией. Лихорадке часто сопутствует изменение психического статуса в виде неадекватности поведения, возбуждения, двигательного беспокойства. Дыхание у больных частое, поверхностное. Артериальное давление нормальное или несколько снижено, тахикардия до ПО ударов в минуту. Темп диуреза снижен до 25 мл/ч. В крови отмечается леГпсоцитоз с высоким уровнем ЛИИ, лимфо- и тромбоцитопения, гипохромия, пойкилоцитоз, компенсированный метаболический ацидоз.
В поздней стадии септического шока (гиподинамическая фаза) гипертермия сменяется гипотермией, отмечается нарушение сознания, вплоть до комы. Кожные покровы бледные с мраморным рисунком. Бледно-цианотичная, холодная кожа, влажные кисти и стопы являются неблагоприятным признаком исхода заболевания. В легких при аускультации определяются рассеянные влажные хрипы, тахипноэ достигает 40-50 в минуту. Систолическое артериальное и пульсовое давление снижено, тахиаритмия выраженная - до 120 ударов в минуту и более.
Со стороны ЖКТ наблюдается развитие пареза кишечника. Уровень билирубина, АЛТ, ACT, ЛДГ возрастает.
Олигурия (менее 10 мл/ч) сопровождается ростом азотемии, снижением концентрационного индекса по осмолярности до 1,0, возрастанием фракционной экскреции натрия выше 2%.
В крови определяется анемия, выраженный лейкоцитоз, лимфопения. Метаболический ацидоз становится декомпенспровапным. Гипергликемия сменяется гипогликемией.
Диагностика септического шока - критерии
Учитывая отсутствие в настоящее время разработанной единой научно обоснованной теории сепсиса, которая позволила бы систематизировать это заболевание, было принято прагматическое решение о достижении согласованного описательного определения сепсиса с целью его единообразной оценки, открывающей возможности проведения эпидемиологических, микробиологических, клинических и других исследований, направленных на совершенствование диагностики и лечения.
Согласно предложению совместной конференции торакального общества и специалистов по интенсивной терапии США, септическим шоком следует считать состояние тяжелого сепсиса (неконтролируемый инфекционный процесс + генерализованная воспалительная реакция + полиорганная дисфункция/недостаточность), сопровождающееся гипотонией (систолическое АД < 90 мм рт. ст. или его снижение на 40 мм рт. ст. и более от исходного), несмотря на адекватную инфузионную поддержку, наряду с присутствием признаков снижения периферического кровотока, которые могут сопровождаться повышением уровня лактата крови, олигурией или нарушением сознания, но не ограничиваться ими.
Пациенты, получающие препараты, повышающие сократительную способность сердца (инотропы) или сосудистый тонус (стимулирующие а- и допаминергические рецепторы), могут иметь признаки периферической гипоперфузии при нормальном АД.
Таким образом, можно выделить четыре ключевых признака развития септического шока (СШ):
- клиническое или лабораторное подтверждение инфекции:
• выделение бактерий из крови, стерильных полостей (плевральной и абдоминальной полостей, субарахноидального пространства, полости сустава) или воспалительных очагов в тканях;
• клинические проявления инфекции (например, перфорация полого органа);
• дополнительные признаки инфекционного заболевания (повышенное количество лейкоцитов в экссудатах из стерильных полостей, признаки пневмонии на рентгенограммах легких и др.);
- признаки генерализованной воспалительной реакции (ГВР):
• температура тела выше 38 °С или ниже 36 С;
• тахикардия более 90 в минуту;
• одышка более 20 в минуту, либо РаСО2 (напряжение углекислого газа в артериальной крови) 32 мм рт. ст. и менее, либо необходимость ИВЛ;
• лейкоцитоз более 12*10 9 /л или менее 4*10 9 /л либо количество юных форм лейкоцитов более 10%.
- артериальная гипотензия, не устраняемая с помощью адекватной по объему инфузии, или необходимость использования вазопрессоров (см. ранее);
- клинико-лабораторные признаки органной гипоперфузии:
• нарушение сознания менее 14 баллов по шкале Глазго (оценивают сумму трех видов активности в баллах: открывание глаз, двигательная активность и речевой ответ). При самостоятельном открывании глаз, способности к адекватной двигательной активности, нормальном речевом контакте выставляют оценку 15 баллов. Нарушение хотя бы одного из указанных видов активности приводит к соответствующему снижению оценки;
• гипотензия: АД + 90 мм рт. ст., либо снижение более чем на 40 мм рт. ст. ниже нормального индивидуального уровня, либо среднее АД ± ± 70 мм рт. ст. (более 1 ч);
• респираторный дистресс-синдром: острое начало, двусторонние инфильтраты на рентгенограмме легких, РаО2 < 70 мм рт. ст. при инсуфляции дыхательной смеси с концентрацией кислорода (FiО2) более 40 %, снижении величины дыхательного коэффициента (PaО2/FiО2 нормальное значение более 300) ниже 200; давление заклинивания легочной артерии (определяется в легочной артерии прямым методом с помощью катетера типа Сван-Ганса) менее 18 мм рт. ст. в отсутствие признаков перегрузки левого желудочка (необходимо исключить инфаркт миокарда и тромбоэмболию легочной артерии как причину перегрузки левого желудочка);
• нешоковое поражение легких: частота дыхания менее 5 или более 50 в минуту; проведение ИВЛ более 3 сут; необходимость инсуффляции дыхательной смеси с повышенным содержанием кислорода (Fi02 > 40 %), необходимость применения респираторной поддержки (ИВЛ) с повышенным положительным давлением в конце выдоха (ПДКВ) более 5 см вод. ст.;
• острая почечная недостаточность: уровень креатинина сыворотки более 280 ммоль/л или необходимость проведения гемофильтрации;
• острая печеночная недостаточность: желтуха, уровень общего билирубина в крови более 51 мкмоль/л или двукратное повышение АЛТ, признаки печеночной энцефалопатии;
• тромбогеморрагический синдром: снижение содержания тромбоцитов на 50 % и более от исходного уровня; увеличение протромбинового времени или активированного частичного тромбопластинового времени на 20 % и более; увеличение концентрации продуктов деградации фибриногена на 20 %, появление D-димеров в концентрации 1:40 или более 500 нг/мл.
Применительно к детям были предложены следующие критерии септического шока (СШ):
- двукратная регистрация артериальной гипотензии (снижение систолического АД более чем на 1/3 от возрастной нормы), или
- необходимость назначения вазопрессоров (за исключением пациентов, получающих допамин в дозе менее 5 мкг/кг в минуту), или - наличие одного и более признаков тяжелого сепсиса.
Признаки тяжелого сепсиса у детей включают наличие синдрома генерализованной воспалительной реакции в сочетании с неврологическими нарушениями (оценка по шкале Глазго менее 14 баллов) либо с повышением уровня лактата в крови более 1,6 ммоль/л), либо со снижением диуреза (менее 1 мл/(кг*ч) в течение 2 ч). Оценку частоты дыхания и сердечных сокращений для диагностики генерализованного воспаления проводят, исходя из границ возрастной нормы.
Внесены уточнения в терминологию и критерии диагноза сепсиса, критерии септического шока (СШ) для детей и новорожденных. С учетом того, что артериальная гипотония у детей развивается поздно и является проявлением декомпенсированного шока, в качестве основополагающих критериев шока принято считать клинические признаки снижения периферической перфузии (снижение уровня сознания, холодные и цианотичные конечности, симптом «белого пятна» продолжительностью более 2 с, снижение диуреза).
Редактор: Искандер Милевски. Дата обновления публикации: 18.3.2021
Септический шок - эпидемиология, смертность
Тяжелый сепсис и септический шок являются актуальной проблемой современной медицины вследствие увеличения количества больных, высокой летальности и возрастания социально-экономических проблем, связанных с лечением и реабилитацией таких пациентов.
Септический шок является жизнеугрожающим состоянием, наиболее тяжелой стадией или формой развития генерализованной инфекции (сепсиса), характеризующейся наличием неконтролируемого инфекционного процесса, реактивного генерализованного воспаления, полиорганной дисфункции/недостаточности и артериальной гипотензии.
До настоящего времени в научной литературе можно встретить несколько терминов, приближающихся по своему значению к термину «септический шок», — это «бактериальный шок», «бактериемический шок», «эндотоксический шок», «эндотоксиновый шок», «инфекционно-токсический шок».
Многообразие сходных названий исторически связано с субъективными факторами: разработкой проблемы сепсиса и септического шока в различных областях медицинской науки, отсутствием до недавнего времени единой классификации сепсиса и объективными факторами — наличием существенных патогенетических различий механизмов развития сепсиса при ряде нозологических форм, недостаточной научной разработкой проблемы септического шока в целом.
Важным шагом к унификации представлений о сепсисе и септическом шоке стали материалы Согласительной конференции Американского торакального общества и Общества специалистов по интенсивной терапии (ACCP/SCCM) в 1991 г., предложившей использовать термин «септический шок» в качестве варианта течения сепсиса. Эта точка зрения нашла поддержку у большинства специалистов и в настоящее время считается общепризнанной.
На этой же конференции были даны определения других стадий инфекции: бактериемии, сепсиса, тяжелого сепсиса, септического шока и синдрома полиорганной дисфункции (СПД). Разработка этих определений открыла новые перспективы как для развития фундаментальных и прикладных научных исследований в области тяжелых инфекций, так и для клинической практики, заложив основу систематической разработки рекомендаций по диагностике и лечению.
Возбудители сепсиса

Эпидемиология септического шока
Септический шок как синдром, стадия или форма заболевания пока не включен в Международную классификацию болезней, поэтому ориентировочные эпидемиологические данные были получены при проведении нескольких многоцентровых проспективных рандомизированных контролируемых исследований с целью оценки эффективности лекарственных препаратов у больных сепсисом. Обнаружено, что пациенты с септическим шоком составляют 58 % от всех больных с тяжелым сепсисом. Математическое моделирование позволило примерно определить количество пациентов с септическим шоком в США — 435 580 человек в год.
Другим источником информации могут быть данные, полученные в ходе международного многоцентрового эпидемиологического исследования 14 364 пациентов в 28 отделениях реанимации и интенсивной терапии (ОРИТ): пациенты с септическим шоком составили 6,3 % от всех больных ОРИТ, причем в 63,2 % случаев септического шока был осложнением нозокомиальных инфекций (НИ). Согласно отечественным данным, доля больных с септическим шоком составила только 26,1 % среди всех пациентов с тяжелым сепсисом.
При включении критериев сепсиса, тяжелого сепсиса и септического шока в программу регистрации пациентов ОРИТ хирургического профиля было обнаружено, что среди 25,9 % пациентов с сепсисом доля больных септическим шоком составила 4,1 %.
Близкие данные по количеству больных септическим шоком приведены в исследованиях многих авторов — 2—4 %, однако имеются данные и о более высоких показателях —7—18 %, что может свидетельствовать о значительной разнородности исследованных групп пациентов.
Летальность в группе больных с септическим шоком. Причиной летальных исходов больных сепсисом и септическим шоком является органная недостаточность, причем комбинация недостаточности нескольких органов увеличивает вероятность летального исхода. В нескольких исследованиях произведена оценка летальности в группе пациентов с септическим шоком по сравнению с больными сепсисом и тяжелым сепсисом. Летальность в группе больных с септическим шоком составила от 46 до 82 %, что в 1,5—2,5 раза превосходило летальность больных тяжелым сепсисом.
Септический шок ( Инфекционно-токсический шок )
Септический шок – это тяжелое патологическое состояние, возникающее при массивном поступлении в кровь бактериальных эндотоксинов. Сопровождается тканевой гипоперфузией, критическим снижением артериального давления и симптомами полиорганной недостаточности. Диагноз ставится на основании общей клинической картины, сочетающей в себе признаки поражения легких, сердечно-сосудистой системы (ССС), печени и почек, централизации кровообращения. Лечение: массивная антибиотикотерапия, инфузия коллоидных и кристаллоидных растворов, поддержание деятельности ССС за счёт введения вазопрессоров, коррекция респираторных нарушений путем ИВЛ.
МКБ-10

Общие сведения
Септический шок (СШ) также называют инфекционно-токсическим (ИТШ). Как самостоятельная нозологическая единица патология впервые была описана в XIX веке, однако полноценное изучение с разработкой специфических противошоковых мер началось не более 25 лет назад. Может возникать при любом инфекционном процессе. Наиболее часто встречается у пациентов хирургических отделений, при менингококковой септицемии, брюшном тифе, сальмонеллезе и чуме. Распространен в странах, где диагностируется наибольшее количество бактериальных и паразитарных заболеваний (Африка, Афганистан, Индонезия). Ежегодно от ИТШ погибает более 500 тысяч человек по всему миру.

Причины
В абсолютном большинстве случаев патология развивается на фоне ослабления иммунных реакций. Это происходит у пациентов, страдающих хроническими тяжелыми заболеваниями, а также у людей пожилого возраста. В силу физиологических особенностей сепсис чаще диагностируется у мужчин. Список самых распространенных заболеваний, при которых могут возникать явления ИТШ, включает в себя:
- Очаги гнойной инфекции. Признаки системной воспалительной реакции и связанных с ней нарушений в работе внутренних органов отмечаются при наличии объемных абсцессов или флегмоны мягких тканей. Риск генерализованного токсического ответа повышается при длительном течении болезни, отсутствии адекватной антибактериальной терапии и возрасте пациента старше 60 лет.
- Длительное пребывание в ОРИТ. Госпитализация в отделение реанимации и интенсивной терапии всегда сопряжена с риском возникновения сепсиса и инфекционного шока. Это обусловлено постоянным контактом с резистентной к антибактериальным препаратам микрофлорой, ослаблением защитных сил организма в результате тяжёлой болезни, наличием множественных ворот инфекции: катетеров, желудочных зондов, дренажных трубок.
- Раны. Нарушения целостности кожных покровов, в том числе возникшие во время операции, существенно повышают риски инфицирования высококонтагиозной флорой. ИТШ начинается у больных с загрязненными ранами, не получивших своевременной помощи. Травматизация тканей в ходе оперативного вмешательства становится причиной генерализованной инфекции только при несоблюдении правил асептики и антисептики. В большинстве случаев септический шок возникает у пациентов, перенесших манипуляции на желудке и поджелудочной железе. Еще одна распространенная причина – разлитой перитонит.
- Приём иммунодепрессантов. Лекарственные средства, угнетающие иммунитет (меркаптопурин, кризанол), используются для подавления реакции отторжения после трансплантации органов. В меньшей степени уровень собственной защиты снижается при употреблении химиотерапевтических средств – цитостатиков, предназначенных для лечения онкологических заболеваний (доксорубицина, фторурацила).
- СПИД.ВИЧ-инфекция в стадии СПИДа приводит к развитию нетипичного сепсиса, спровоцированного не бактериальный культурой, а грибком рода Candida. Клинические проявления болезни характеризуется малой степенью выраженности. Отсутствие адекватного иммунного ответа позволяет патогенной флоре свободно размножаться.
Возбудитель сепсиса – грамположительные (стрептококки, стафилококки, энтерококки) и грамотрицательные (Enterobacter cloacae, Clostridium pneumoniae) бактерии. Во многих случаях культуры нечувствительны к антибиотикам, что затрудняет лечение пациентов. Септический шок вирусного происхождения в настоящее время вызывает споры специалистов. Одни представители научного мира утверждают, что вирусы неспособны стать причиной патологии, другие – что внеклеточная форма жизни может спровоцировать системную воспалительную реакцию, являющуюся патогенетической основой ИТШ.
Патогенез
В основе симптомов лежит неконтролируемое распространение медиаторов воспаления из патологического очага. При этом происходит активация макрофагов, лимфоцитов и нейтрофилов. Возникает синдром системного воспалительного ответа. На фоне этого снижается периферический сосудистый тонус, объем циркулирующей крови падает за счет повышения проницаемости сосудов и застоя жидкости в микроциркуляторном русле. Дальнейшие изменения обусловлены резким уменьшением перфузии. Недостаточное кровоснабжение становится причиной гипоксии, ишемии внутренних органов и нарушения их функции. Наиболее чувствителен головной мозг. Кроме того, ухудшается функциональная активность легких, почек и печени.
Помимо СВР в формировании септического шока важную роль играет эндогенная интоксикация. В связи со снижением работоспособности экскреторных систем в крови накапливаются продукты нормального обмена веществ: креатинин, мочевина, лактат, гуанин и пируват. Во внутренних средах повышается концентрация промежуточных результатов окисления липидов (скатол, альдегиды, кетоны) и бактериальных эндотоксинов. Всё это вызывает тяжелые изменения гомеостаза, расстройства кислотно-щелочного баланса, нарушения в работе рецепторных систем.
Классификация
Шоковое состояние классифицируется по патогенетическому и клиническому принципу. Патогенетически болезнь может быть «теплой» и «холодной». Тёплый шок характеризуется увеличением сердечного выброса на фоне снижения общего сосудистого тонуса, эндогенной гиперкатехоламинемией и расширением внутрикожных сосудов. Явления органной недостаточности выражены умеренно. Холодная разновидность проявляется снижением сердечного выброса, резким ослаблением тканевой перфузии, централизацией кровообращения и тяжелой ПОН. По клиническому течению септический шок подразделяется на следующие разновидности:
Симптомы септического шока
90% случаев СШ сопровождается дыхательной недостаточностью различной степени тяжести. Пациенты с декомпенсированным и терминальным течением болезни нуждаются в аппаратной респираторной поддержке. Печень и селезенка увеличены, уплотнены, их функция нарушена. Может отмечаться атония кишечника, метеоризм, стул с примесью слизи, крови и гноя. На поздних стадиях возникают симптомы диссеминированного внутрисосудистого свертывания: петехиальная сыпь, внутреннее и наружное кровотечения.
Осложнения
Септический шок приводит к ряду тяжелых осложнений. Наиболее распространённым из них считается полиорганная недостаточность, при которой нарушается функция двух и более систем. В первую очередь страдает ЦНС, легкие, почки и сердце. Несколько реже встречается поражение печени, кишечника и селезенки. Летальность среди пациентов с ПОН достигает 60%. Часть из них погибает на 3-5 сутки после выведения из критического состояния. Это обусловлено органическими изменениями во внутренних структурах.
Еще одним распространенным последствием ИТШ являются кровотечения. При формировании внутримозговых гематом у пациента развивается клиника острого геморрагического инсульта. Скопление экстравазата в других органах может приводить к их сдавлению. Уменьшение объема крови в сосудистом русле потенцирует более значимое снижение артериального давления. ДВС на фоне инфекционно-токсического шока становится причиной гибели пациента в 40-45% случаев. Вторичное поражение органов, спровоцированное микротромбозами, возникающими на начальном этапе формирования коагулопатии, отмечается практически у 100% больных.
Диагностика
Диагноз устанавливается врачом анестезиологом-реаниматологом. Предположение строится на клинических данных, однако с точностью определить имеющееся состояние можно только при наличии результатов аппаратного и лабораторного исследований. При подозрении на септический шок все анализы делаются в экстренном режиме, «по cito». Реанимационные мероприятия следует начинать, не дожидаясь окончания работы вспомогательных служб. Комплексное обследование, необходимое для определения и подтверждения ИТШ, включает в себя:
- Осмотр и физикальное исследование. Реализуется непосредственно лечащим врачом. Специалист обнаруживает характерные клинические признаки шокового состояния. Для этого проводится тонометрия, визуальная оценка цвета кожных покровов, особенностей дыхательных движений, подсчет пульса и ЧДД, аускультация сердца и легких. При подозрении на наличие осложнений необходима оценка неврологического статуса на предмет симптоматики кровоизлияния в мозг.
- Аппаратное исследование. Имеет вспомогательное значение. Пациенту показан контроль состояния с использованием анестезиологического монитора. На экран устройства выводится информация о величине артериального давления, частоте сердечных сокращений, степени насыщения крови кислородом (при легочной недостаточности SpO2<90%) и коронарном ритме. На фоне нарушений дыхания и токсического поражения миокарда может отмечаться тахикардия, аритмия и блокады внутрисердечной проводимости.
- Лабораторное исследование. Позволяет выявить имеющиеся нарушения гомеостаза, сбои в работе внутренних органов. У пациентов с шоком септического происхождения обнаруживается повышенный уровень креатинина (> 0,177 ммоль/л), билирубина (>34,2 мкмоль/л), лактата (>2 ммоль/л). О нарушении коагуляции свидетельствует тромбоцитопения (
Лечение септического шока
Пациентам показана интенсивная терапия. Лечение проводят в отделениях ОРИТ с использованием методов аппаратной и медикаментозной поддержки. Лечащий врач – реаниматолог. Может потребоваться консультация инфекциониста, кардиолога, гастроэнтеролога и других специалистов. Требуется перевод больного на искусственную вентиляцию лёгких, круглосуточное наблюдение среднего медицинского персонала, парентеральное кормление. Смеси и продукты, предназначенные для введения в желудок, не используются. Все методы воздействия условно делятся на патогенетические и симптоматические:
- Патогенетическое лечение. При подозрении на наличие сепсиса больному назначают антибиотики. Схема должна включать в себя 2-3 препарата различных групп, обладающих широким спектром действия. Подбор медикамента на начальном этапе проводят эмпирическим путем, в соответствии с предполагаемой чувствительностью возбудителя. Одновременно с этим производят забор крови на стерильность и восприимчивость к антибиотикам. Результат анализа готовится в течение 10 дней. Если к этому времени подобрать эффективную лекарственную схему не удалось, следует использовать данные исследования.
- Симптоматическое лечение. Подбирается с учетом имеющейся клинической картины. Обычно больные получают массивную инфузионную терапию, глюкокортикостероиды, инотропные средства, антиагреганты или гемостатики (в зависимости от состояния свертывающей системы крови). При тяжелом течении болезни используют препараты крови: свежезамороженную плазму, альбумин, иммуноглобулины. Если пациент находится в сознании, показано введение анальгетических и седативных лекарств.
Прогноз и профилактика
Септический шок имеет неблагоприятный прогноз для жизни. При субкомпенсированном течении погибает около 40% больных. Декомпенсированная и терминальная разновидности оканчиваются гибелью 60% пациентов. При отсутствии своевременной медицинской помощи смертность достигает 95-100%. Часть больных умирает через несколько дней после устранения патологического состояния. Профилактика ИТШ заключается в своевременном купировании очагов инфекции, грамотном подборе антибиотикотерапии у хирургических больных, соблюдении антисептических требований в отделениях, занимающихся инвазивным манипуляциями, поддержке адекватного иммунного статуса у представителей ВИЧ-инфицированной прослойки населения.
2. Тактика ведения пациентов с сепсисом и септическим шоком в многопрофильном стационаре/ Сапичева Ю.Ю., Лихванцев В.В. – 2015.
Сепсис
Сепсис - общая гнойная инфекция, развивающаяся вследствие проникновения и циркуляции в крови различных возбудителей и их токсинов. Клиническая картина сепсиса складывается из интоксикационного синдрома (лихорадки, ознобов, бледно-землистой окраски кожных покровов), тромбогеморрагического синдрома (кровоизлияний в кожу, слизистые, конъюнктиву), метастатического поражения тканей и органов (абсцессов различных локализаций, артритов, остеомиелитов и др.). Подтверждением сепсиса служит выделение возбудителя из культуры крови и локальных очагов инфекции. При сепсисе показано проведение массивной дезинтоксикационной, антибактериальной терапии, иммунотерапии; по показаниям – хирургическое удаление источника инфекции.



Сепсис (заражение крови) – вторичное инфекционное заболевание, вызванное попаданием патогенной флоры из первичного локального инфекционного очага в кровяное русло. Сегодня ежегодно в мире диагностируется от 750 до 1,5 млн. случаев сепсиса. По статистике, чаще всего сепсисом осложняются абдоминальные, легочные и урогенитальные инфекции, поэтому данная проблема наиболее актуальная для общей хирургии, пульмонологии, урологии, гинекологии. В рамках педиатрии изучаются проблемы, связанные с сепсисом новорожденных. Несмотря на использование современных антибактериальных и химиотерапевтических препаратов, летальность от сепсиса остается на стабильно высоком уровне – 30-50%.

Причины сепсиса
Важнейшими факторами, приводящими к срыву противоинфекционной резистентности и развитию сепсиса, выступают:
- со стороны макроорганизма - наличие септического очага, периодически или постоянно связанного с кровяным или лимфатическим руслом; нарушенная реактивность организма
- со стороны инфекционного возбудителя – качественные и количественные свойства (массивность, вирулентность, генерализация по крови или лимфе)
Ведущая этиологическая роль в развитии большинства случаев сепсиса принадлежит стафилококкам, стрептококкам, энтерококкам, менингококкам, грамотрицательной флоре (синегнойной палочке, кишечной палочке, протею, клебсиелле, энтеробактер), в меньшей степени - грибковым возбудителям (кандидам, аспергиллам, актиномицетам).
Выявление в крови полимикробных ассоциаций в 2,5 раза увеличивает уровень летальности больных сепсисом. Возбудители могут попадать в кровь из окружающей среды или заноситься из очагов первичной гнойной инфекции.
Велико значение внутрибольничной инфекции: ее росту способствует широкое применение инвазивных диагностических процедур, иммуносупрессивных лекарственных препаратов (глюкокортикоидов, цитостатиков). В условиях иммунодефицита, на фоне травмы, операционного стресса или острой кровопотери инфекция из хронических очагов беспрепятственно распространяется по организму, вызывая сепсис. Развитию сепсиса более подвержены недоношенные дети, больные, длительно находящиеся на ИВЛ, гемодиализе; онкологические, гематологические пациенты; больные сахарным диабетом, ВИЧ-инфекцией, первичными и вторичными иммунодефицитами.
Механизм развития сепсиса многоступенчатый и очень сложный. Из первичного инфекционного очага патогены и их токсины проникают в кровь или лимфу, обуславливая развитие бактериемии. Это вызывает активацию иммунной системы, которая реагирует выбросом эндогенных веществ (интерлейкинов, фактора некроза опухолей, простагландинов, фактора активации тромбоцитов, эндотелинов и др.), вызывающих повреждение эндотелия сосудистой стенки. В свою очередь, под воздействием медиаторов воспаления активизируется каскад коагуляции, что в конечном итоге приводит к возникновению ДВС-синдрома. Кроме этого, под влиянием высвобождающихся токсических кислородсодержащих продуктов (оксида азота, перекиси водорода, супероксидов) снижается перфузия, а также утилизация кислорода органами. Закономерным итогом при сепсисе является тканевая гипоксия и органная недостаточность.
Формы сепсиса классифицируются в зависимости от локализации первичного инфекционного очага. На основании этого признака различают первичный (криптогенный, эссенциальный, идиопатический) и вторичный сепсис. При первичном сепсисе входные ворота обнаружить не удается. Вторичный септический процесс подразделяется на:
- хирургический – развивается при заносе инфекции в кровь из послеоперационной раны
- акушерско-гинекологический – возникает после осложненных абортов и родов
- уросепсис – характеризуется наличием входных ворот в отделах мочеполового аппарата (пиелонефрит, цистит, простатит)
- кожный – источником инфекции служат гнойные заболевания кожи и поврежденные кожные покровы (фурункулы, абсцессы, ожоги, инфицированные раны и др.)
- перитонеальный (в т. ч. билиарный, кишечный) – с локализацией первичных очагов в брюшной полости
- плевро-легочный – развивается на фоне гнойных заболеваний легких (абсцедирующей пневмонии, эмпиемы плевры и др.)
- одонтогенный– обусловлен заболеваниями зубочелюстной системы (кариесом, корневыми гранулемами, апикальным периодонтитом, периоститом, околочелюстными флегмонами, остеомиелитом челюстей)
- тонзиллогенный – возникает на фоне тяжелых ангин, вызванных стрептококками или стафилококками
- риногенный – развивается вследствие распространения инфекции из полости носа и придаточных пазух, обычно при синуситах
- отогенный - связан с воспалительными заболеваниями уха, чаще гнойным средним отитом.
- пупочный– встречается при омфалите новорожденных
По времени возникновения сепсис подразделяется на ранний (возникает в течение 2-х недель с момента появления первичного септического очага) и поздний (возникает позднее двухнедельного срока). По темпам развития сепсис может быть молниеносным (с быстрым развитием септического шока и наступлением летального исхода в течение 1-2 суток), острым (длительностью 4 недели), подострым (3-4 месяца), рецидивирующим (продолжительностью до 6 месяцев с чередованием затуханий и обострений) и хроническим (продолжительностью более года).
Сепсис в своем развитии проходит три фазы: токсемии, септицемии и септикопиемии. Фаза токсемии характеризуется развитием системного воспалительного ответа вследствие начала распространения микробных экзотоксинов из первичного очага инфекции; в этой фазе бактериемия отсутствует. Септицемия знаменуется диссеминацией возбудителей, развитием множественных вторичных септических очагов в виде микротромбов в микроциркуляторном русле; наблюдается стойкая бактериемия. Для фазы септикопиемии характерно образование вторичных метастатических гнойных очагов в органах и костной системе.
Симптомы сепсиса
Симптоматика сепсиса крайне полиморфна, зависит от этиологической формы и течения заболевания. Основные проявления обусловлены общей интоксикацией, полиорганными нарушениями и локализацией метастазов.
Состояние больного сепсисом быстро утяжеляется. Кожные покровы приобретают бледновато-серый (иногда желтушный) цвет, черты лица заостряются. Могут возникать герпетические высыпания на губах, гнойнички или геморрагические высыпания на коже, кровоизлияния в конъюнктиву и слизистые оболочки. При остром течении сепсиса у больных быстро возникают пролежни, нарастает обезвоживание и истощение.
В условиях интоксикации и тканевой гипоксии при сепсисе развиваются полиорганные изменения различной степени тяжести. На фоне лихорадки отчетливо выражены признаки нарушения функций ЦНС, характеризующиеся заторможенностью или возбуждением, сонливостью или бессонницей, головными болями, инфекционными психозами и комой. Сердечно-сосудистые нарушения представлены артериальной гипотонией, ослаблением пульса, тахикардией, глухостью сердечных тонов. На этом этапе сепсис может осложниться токсическим миокардитом, кардиомиопатией, острой сердечно-сосудистой недостаточностью.
На происходящие в организме патологические процессы дыхательная система реагирует развитием тахипноэ, инфаркта легкого, респираторного дистресс-синдрома, дыхательной недостаточности. Со стороны органов ЖКТ отмечается анорексия, возникновение «септических поносов», чередующихся с запорами, гепатомегалии, токсического гепатита. Нарушение функции мочевыделительной системы при сепсисе выражается в развитии олигурии, азотемии, токсического нефрита, ОПН.
В первичном очаге инфекции при сепсисе также происходят характерные изменения. Заживление ран замедляется; грануляции становятся вялыми, бледными, кровоточащими. Дно раны покрывается грязно-сероватым налетом и участками некрозов. Отделяемое приобретает мутный цвет и зловонный запах.
Метастатические очаги при сепсисе могут выявляться в различных органах и тканях, что обусловливает наслоение дополнительной симптоматики, свойственной гнойно-септическому процессу данной локализации. Следствием заноса инфекции в легкие служит развитие пневмонии, гнойного плеврита, абсцессов и гангрены легкого. При метастазах в почки возникают пиелиты, паранефриты. Появление вторичных гнойных очагов в опорно-двигательной системе сопровождается явлениями остеомиелита и артрита. При поражении головного мозга отмечается возникновение церебральных абсцессов и гнойного менингита. Возможно наличие метастазов гнойной инфекции в сердце (перикардит, эндокардит), мышцах или подкожной жировой клетчатке (абсцессы мягких тканей), органах брюшной полости (абсцессы печени и др.).
Осложнения сепсиса
Основные осложнения сепсиса связаны с полиорганной недостаточностью (почечной, надпочечниковой, дыхательной, сердечно-сосудистой) и ДВС-синдромом (кровотечения, тромбоэмболии).
Тяжелейшей специфической формой сепсиса является септический (инфекционно-токсический, эндотоксический) шок. Он чаще развивается при сепсисе, вызванном стафилококком и грамотрицательной флорой. Предвестниками септического шока служат дезориентация больного, видимая одышка и нарушение сознания. Быстро нарастают расстройства кровообращения и тканевого обмена. Характерны акроцианоз на фоне бледных кожных покровов, тахипноэ, гипертермия, критическое падение АД, олигурия, учащение пульса до 120-160 уд. в минуту, аритмия. Летальность при развитии септического шока достигает 90%.

Диагностика сепсиса
Распознавание сепсиса основывается на клинических критериях (инфекционно-токсической симптоматике, наличии известного первичного очага и вторичных гнойных метастазов), а также лабораторных показателях (посев крови на стерильность).
Вместе с тем, следует учитывать, что кратковременная бактериемия возможна и при других инфекционных заболеваниях, а посевы крови при сепсисе (особенно на фоне проводимой антибиотикотерапии) в 20-30% случаев бывают отрицательными. Поэтому посев крови на аэробные и анаэробные бактерии необходимо проводить минимум трехкратно и желательно на высоте лихорадочного приступа. Также производится бакпосев содержимого гнойного очага. В качестве экспресс-метода выделения ДНК возбудителя сепсиса используется ПЦР. В периферической крови отмечается нарастание гипохромной анемии, ускорение СОЭ, лейкоцитоз со сдвигом влево.
Дифференцировать сепсис необходимо от лимфогранулематоза, лейкемии, брюшного тифа, паратифов А и В, бруцеллеза, туберкулеза, малярии и других заболеваний, сопровождающихся длительной лихорадкой.
Лечение сепсиса
Пациенты с сепсисом госпитализируются в отделение интенсивной терапии. Комплекс лечебных мероприятий включает в себя антибактериальную, дезинтоксикационную, симптоматическую терапию, иммунотерапию, устранение белковых и водно-электролитных нарушений, восстановление функций органов.
С целью устранения источника инфекции, поддерживающего течение сепсиса, проводится хирургическое лечение. Оно может заключаться во вскрытии и дренировании гнойного очага, выполнении некрэктомии, вскрытии гнойных карманов и внутрикостных гнойников, санации полостей (при абсцессе мягких тканей, флегмоне, остеомиелите, перитоните и др.). В некоторых случаях может потребоваться резекция или удаление органа вместе с гнойником (например, при абсцессе легкого или селезенки, карбункуле почки, пиосальпинксе, гнойном эндометрите и др.).
Борьба с микробной флорой предполагает назначение интенсивного курса антибиотикотерапии, проточное промывание дренажей, местное введение антисептиков и антибиотиков. До получения посева с антибиотикочувствительностью терапию начинают эмпирически; после верификации возбудителя при необходимости производится смена противомикробного препарата. При сепсисе для проведения эмпирической терапии обычно используются цефалоспорины, фторхинолоны, карбапенемы, различные комбинации препаратов. При кандидосепсисе этиотропное лечение проводится амфотерицином В, флуконазолом, каспофунгином. Антибиотикотерапия продолжается в течение 1-2 недель после нормализации температуры и двух отрицательных бакпосевов крови.
Дезинтоксикационная терапия при сепсисе проводится по общим принципам с использованием солевых и полиионных растворов, форсированного диуреза. С целью коррекции КОС используются электролитные инфузионные растворы; для восстановления белкового баланса вводятся аминокислотные смеси, альбумин, донорская плазма. Для борьбы с бактериемией при сепсисе широко используются процедуры экстракорпоральной детоксикации: плазмаферез, гемосорбция, гемофильтрация. При развитии почечной недостаточности применяется гемодиализ.
Иммунотерапия предполагает использование антистафилококковой плазмы и гамма-глобулина, переливание лейкоцитарной массы, назначение иммуностимуляторов. В качестве симптоматических средств используются сердечно-сосудистые препараты, анальгетики, антикоагулянты и др. Интенсивная медикаментозная терапия при сепсисе проводится до стойкого улучшения состояния больного и нормализации показателей гомеостаза.
Исход сепсиса определяется вирулентностью микрофлоры, общим состоянием организма, своевременностью и адекватностью проводимой терапии. К развитию осложнений и неблагоприятному прогнозу предрасположены больные пожилого возраста, с сопутствующими общими заболеваниями, иммунодефицитами. При различных видах сепсиса летальность составляет 15-50%. При развитии септического шока вероятность летального исхода крайне высока.
Профилактические меры в отношении сепсиса состоят в устранении очагов гнойной инфекции; правильном ведении ожогов, ран, локальных инфекционно-воспалительных процессов; соблюдении асептики и антисептики при выполнении лечебно-диагностических манипуляций и операций; предупреждении госпитальной инфекции; проведении вакцинации (против пневмококковой, менингококковой инфекции и др.).
Читайте также:
